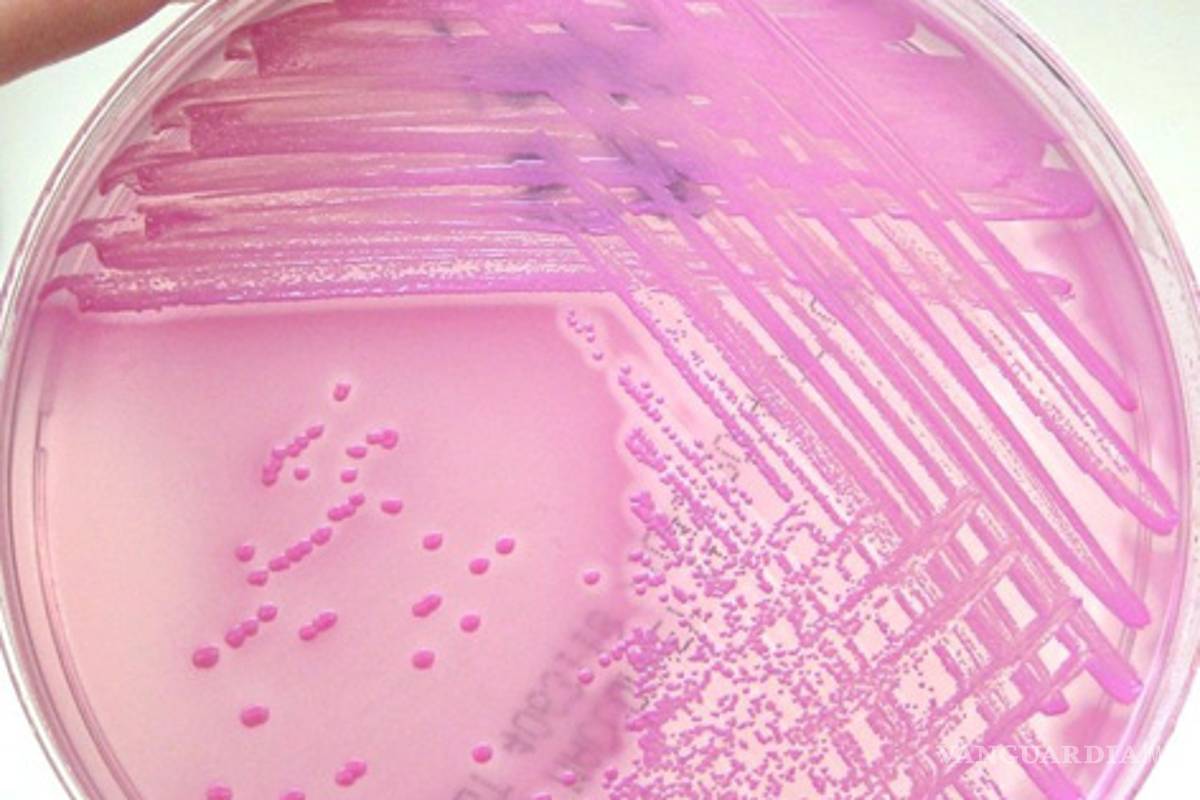
`La guerra del pepino' amenaza el comercio en Europa

`La guerra del pepino' amenaza el comercio en Europa
COMPARTIR
España reclamó a la Unión Europea un resarcimiento por lo que consideró un "daño irreparable" a su reputación como productor. Rusia cerró las importaciones de vegetales contaminados
Las autoridades españolas se quejan por la inexistencia de pruebas que vinculen su producción de pepinos con las 11 muertes registradas en Alemania. Los funcionarios temen que se trate de una disputa comercial.
"No sé por qué les resulta más atractivo a todos salir contra España, contra Andalucía y contra Almería. Espero que no tenga nada que ver con los intereses comerciales" sostuvo Clara Aguilera, consejera andaluza de Agricultura.
En la última semana se conocieron 11 casos fatales de infección con Escherichia coli, una bacteria generalmente inofensiva. Sin embargo, algunas cepas pueden generar cuadros de síndrome urémico hemolítico, una enfermedad que produce hemorragias y puede causar la muerte.                                                                                  Â
En la actualidad, se realizan estudios a la producción de 13 invernaderos en Almería y Andalucía de donde proceden los pepinos que habrían ocasionado las infecciones en Alemania. Los resultados serán conocidos el jueves.
Los ministros de Agricultura europeos esperan poder controlar la situación y se reúnen en Budapest el lunes. Allí la responsable española protestará por las acusaciones vertidas contra su país.
Rusia decidió prohibir el paso de cargamentos hortícolas españoles o alemanes a través de sus fronteras. Las autoridades aduaneras recibieron la orden expresa de frenar cualquier ingreso de ese tipo.
"Si la situación no cambia, prohibiremos todas las verduras europeas" sostuvo el jefe del servicio sanitario ruso, Guenadi Onichshenko.
El funcionario acusó a la Unión Europea de no suministrar explicaciones razonables respecto de la causa del brote. Hasta el momento los afectados ascienden a unas 1.200 personas.
"Le pedimos a la población que no compre verduras frescas de Alemania y España. Que compre productos nacionales", agregó Onichshenko.








